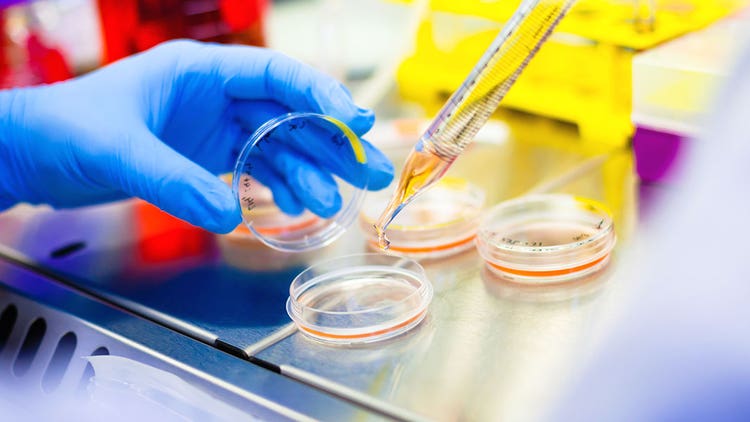

Introduction to Stem Cells
Stem cells can differentiate into various cell types, making them crucial for therapeutic and research applications. They can be found in various tissues and organs, including bone marrow, umbilical cord blood and embryonic tissue.
Stem cells hold great promise in the regenerative medicine field for their potential to replace, repair or regenerate damaged or diseased cells, tissues and organs. They also have the potential to be used for the treatment of a wide range of diseases, including cancer, neurodegenerative disorders and cardiovascular disease.
Research on stem cells is challenging and has limits. Not all stem cells can divide indefinitely or give rise to every cell type. Nor are all stem cells ubiquitously distributed throughout the body. New research continues to elucidate the basic mechanisms of stem cell biology.
Types of Stem Cells
Stem cells are undifferentiated or progenitor cells that have the capacity to give rise to specialized cells. There are three main types of stem cells: embryonic, adult and induced pluripotent.
Embryonic stem cells are derived from the inner cell mass of a blastocyst. These cells have the unique ability to differentiate into all cell types found in the human body and have therefore been considered a potential source for regenerative medicine.
Adult stem cells are found in various tissues and organs throughout the body and have more limited differentiation potential. They serve as a sort of internal repair system, replenishing other cells as they die or are damaged. For example, hematopoietic stem cells in bone marrow can give rise to all blood cell types, while mesenchymal stem cells in bone marrow can differentiate into bone, cartilage and fat cells.
Induced pluripotent stem cells (iPSCs) are adult cells that have been genetically reprogrammed to an embryonic stem cell-like state. iPSCs have the same capacity to differentiate into various cell types as embryonic stem cells but are derived from a patient's own cells, which eliminates the need for a matched donor and reduces the risk of rejection.
Embryonic Stem Cells
There are two types of embryonic stem cells: Totipotent & Pluripotent.
-
Totipotent Stem Cells are embryonic stem cells that are present in the initial embryo development. A totipotent stem cell can divide and produce all the cells in the body, including extraembryonic cells (placenta and embryo).
-
Pluripotent Stem Cells are derived from the inner cell mass of a blastocyst and can differentiate into any cell type in the body but cannot form a new organism.
Adult Stem Cells
Adult stem cells are found in various tissues throughout the body and typically give rise to cell types specific to that tissue.
- Hematopoietic Stem Cells used in bone marrow transplants give rise to all blood cell types.
- Mesenchymal Stem Cells (MSCs) are a type of adult stem cell that can be found in many tissues throughout the body, including the bone marrow, adipose tissue and cord blood. MSCs can differentiate into various types of cells, including osteoblasts (bone cells), chondrocytes (cartilage cells) and adipocytes (fat cells). Mesenchymal stem cells have been used for immunomodulation in clinical trials to treat autoimmune diseases and graft-versus-host disease.
Featured Product
Stem Cells

THUNDER Imager Live Cell & 3D Assay
With THUNDER Imagers you begin every experiment with confidence. They are your solution for advanced 3D cell culture assays, whether you want to study stem cells, spheroids, or organoids.
THUNDER Imagers feature the innovative Leica technology Computational Clearing. It efficiently removes out-of-focus blur in real time, enabling the meaningful use of 3D specimens with camera-based fluorescence microscopes. The high sensitivity of the system ensures low phototoxicity and photobleaching, i.e., higher throughput with optimal conditions.


See how Danaher Life Sciences can help
Induced Pluripotent Stem Cells
Induced pluripotent stem cells (iPSCs) can be derived from mature cells in the body and have been used to generate many different types of cells and tissues for research and therapeutic purposes.
The main advantage of iPSCs over other types of stem cells is that they can be generated from a patient's own cells, which reduces the risk of immune rejection. Additionally, iPSCs can be used to create models of diseases that can then be utilized for drug discovery and testing.
Producing iPSCs involves several steps.
- Cell isolation: The first step is to obtain the adult cells that will be reprogrammed into iPSCs. This is typically done by isolating cells from a tissue sample, such as skin or blood.
- Reprogramming: The adult cells are then reprogrammed into iPSCs by introducing specific genes with viral vectors or molecules that can ‘reprogram’ the cells to a pluripotent state. Direct reprogramming with the Yamanaka factors (Oct4, Sox2, Klf4, c-Myc) has traditionally been used to generate iPSCs but additional reprogramming genes have been utilized.
- Culturing: Once the cells have been reprogrammed, they are placed in a culture dish and grown under specific conditions to promote the growth and proliferation of the iPSCs.
- Characterization: The resulting iPSCs are then characterized and verified for pluripotency, including testing the ability of the iPSCs to differentiate into multiple cell types.
Stem Cell Therapy Research
Stem cell therapy is a rapidly growing field of research with the potential to treat various medical conditions. Stem cells can differentiate into a wide range of cell types and are an attractive option for regenerative medicine and personalized therapies.
Regenerative Medicine
One of the key benefits of stem cell therapy is its potential to replace or repair damaged tissues and organs. For example, researchers are exploring the use of stem cells to treat conditions such as heart disease, Parkinson's disease and spinal cord injury. When a tissue is damaged, stem cells can be recruited to the site of injury, where they proliferate and differentiate into the specific cell type(s) needed for repair. Some injury sites have local progenitor populations or recruit mature cells to sites of damage to facilitate repair.
Applications in Cancer Treatment
In addition to regenerative medicine, stem cell therapy also shows potential in research for cancer treatment. Researchers are exploring the use of stem cells to deliver therapeutic agents directly to the tumor site in a strategy known as stem cell-mediated drug delivery. This approach has the potential to increase the effectiveness of cancer treatments while reducing their toxicity, leading to improved outcomes for patients.
Improved Treatments for Genetic Disorders
Stem cell therapy also has the potential to contribute to the development of new and improved treatments for genetic disorders. By using stem cells to study the underlying mechanisms of these conditions, researchers can gain a deeper understanding of the diseases and identify new targets for therapy. Additionally, stem cell-based screening assays can be used to test the efficacy and safety of new drugs in a controlled and reproducible manner, reducing the time and cost of drug development.
Stem Cell Engineering
Stem cell engineering refers to the use of various techniques to manipulate and control the behavior of stem cells to achieve specific goals, such as producing specific cell types or treating diseases. Some of the methods used in stem cell engineering include:
- Gene Editing: Using tools such as CRISPR-Cas9 to introduce specific genetic changes in the stem cells. This can be used to correct genetic mutations that cause diseases or to introduce new genetic traits that could be useful for therapy.
- Directed Differentiation: Using various chemical and physical cues, such as specific growth factors or extracellular matrix proteins, to coax stem cells to differentiate into specific cell types. This can be used to produce specific types of cells for use in research or therapy.
- Tissue Engineering: Using stem cells in combination with other materials, such as hydrogels or scaffolds to create replacement tissues and organs.
Application to Stem Cells
There are many potential future applications for stem cells as scientists continue to explore their vast potential to improve human health. Some of the most promising areas of new and continuing research include:
- Regenerative Medicine: New research continues to investigate the use of stem cells to affect repair or regeneration in a wide range of tissues and organs, including the heart, liver, lungs and skin.
- Organ Transplants: Scientists are working to develop techniques for growing replacement organs using iPSCs. This could potentially help lower the need for organ donors and reduce the risk of rejection of transplanted organs.
- Drug Development and Toxicity Testing: Stem cells can be used to create 3D cell cultures (organoids) that more closely mimic the physiology of tissues in the body. This can be used to test the safety and efficacy of new drugs and identify potential side effects
- Disease Modeling: Stem cells are being used to create in vitro models of human diseases, which can be used to study the underlying causes to develop new treatments
- Personalized Medicine: Stem cells can potentially be used to create patient-specific cell lines that can be used to test the effectiveness of different treatments for a particular individual.